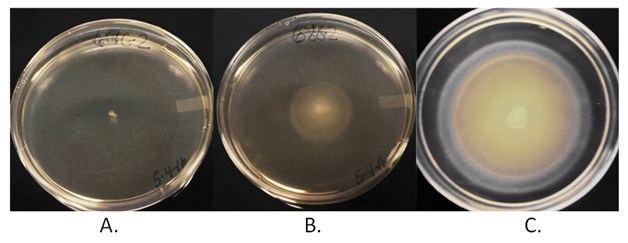

Journal of
eISSN: 2469 - 2786


Research Article Volume 5 Issue 3
1Cancer Research Center, USA
2University of Missouri-Columbia, USA
Correspondence: Habip Gedik, Associate Professor, Department of Infectious Diseases and Clinical Microbiology, Ministry of Health Bak?rköy Sadi Konuk Training and Research Hospital, ?stanbul, Turkey, Tel 00 90 505 336 27 70, Tel (573) 8752255
Received: June 07, 2017 | Published: August 21, 2017
Citation: Eisenstark A, Mehr JK, Ransdell J. The immortal Salmonella typhimurium. (Amnesia among resting cells). J Bacteriol Mycol Open Access. 2017;5(3):299-301. DOI: 10.15406/jbmoa.2017.05.00135
Our laboratory contains a collection of thousands of Salmonella typhimurium LT2 and LT7cultures, including mutants (the Demerec collection). Milislav Demerec started the collection of mutants over five decades ago at Carnegie Institute of Genetics, Cold Spring Harbor, L.I., NY. Upon his retirement, Dr. Demerec and the collection moved to Brookhaven National Laboratories. Upon Dr. Demerec’s death, the collection (archived in quintuplicate) was divided and distributed to Kenneth Sanderson (who now maintains the official Salmonella Center, Calgary, Canada), Philip Hartman, Princeton University, and to Abraham Eisenstark, U. Missouri (see History of Collection, below). Thus, each of us had a complete collection.
Keywords: salmonella typhimurium, archival storage, viability, aged bacteria
These cultures of Salmonella typhimurium, both wild type and mutants, were stored mainly for the ability to start fresh cultures and to note any genomic changes that may have occurred during storage. In this report there is no intent to relate to any evolutionary events. To do this would require precisely designed experimental methods. In addition to this brief Mini Review, we now report an example use of these archived Salmonella mutants in exploring genomic changes among survivors after the last 4-6 decades of storage in LB agar stabs stored in sealed small tubes (Eisenstark lab), the genomic change results observed in recent experiments (with co-investigators, J. Kian Mehr and J. Ransdell). The successful use of immortal HeLa cells in research initiated deliberation about life in assumed non-viable cells. After decades of stem cell research, scientists are deliberating the use of mammalian skin stem cells even in the initiation of normal baby dogs and perhaps human babies.
Our research efforts have focused on immortality among bacterial cells. In search of survival strategies, our recent studies revealed numerous mutations in Salmonella typhimurium cells that had been sealed in LB agar stab vials and stored for the last 4-6 decades. The mutant isolates that were conserved in over 20,000 vials were progeny derived from the same S. typhimurium LT2 and LT7 strains (Figure 1).
Note – Figure 1 can go here. + legend

Figure 1 Sample of storage of archived cultures of S. typhimurium LT2 and LT7. Over 2000 vials remain in 10 boxes containingimmortal cultures that remain important for genomic studies.
Among studies in our laboratory of decades-old archived cultures of resting stage Salmonella typhimurium LT2, we have observed a series of diverse mutation patterns. The mutations included deletions, duplications, frame shifts, inversions and transpositions, and losses in carbon and nitrogen metabolism.1-6
Most recently, an archived genetically engineered strain of LT2 has been used to target and impede metastasis in human prostate tumor cells.7,8
(This history is now archived by American Society of Microbiology in a series of letters from Joshua Lederberg). To inaugurate the collection, the initial Lilleengen Salmonella typhimurium LT1-LT23was sent to Demerec by Joshua Lederberg, who obtained them through the Swedish Embassy. From these, Demerec and colleagues chose LT2 to construct a gene linkage map, using the newly discovered transducing phage P22.9 Phage P22 was found in the glycogenic P22 strain.
In addition to the use of the archived strains, standard bacteriology materials and methods were used.10 In a recent experiment, 100 new archived tubes of S. typhimuriumLT2were opened, one-third after storage of 19 months, another third after 33 months, and another third after 12 years and nine months. The methods for scoring genomic changes are described under Results.
For this mini review, earlier results will only be summarized, and below are the results from the 100 newly archived tubes. Note that samples were taken at three different time periods. The basis for this was to verify that, with increasing time, there was increasing variance in phenotypes. For decades, experiments using these archived mutants have provided interesting insights on genomic changes that occur in assumed dormancy.1-6,11 In our most recent set of experiments, we focused on scoring three specific phenotypic changes:
Lls are touched on LB agar plate, as observed in Figure 2.
Phage Tests
Although phage testing has been a very useful scheme for identifying differences among bacterial strains, it displayed fewer differences in his case than either of the other two tests. The phage that we chose is listed in Table 1. We used these to phage test 65 archived strains.
Figure 2 This migration phenotype was chosen because different migration patterns reflected a mutation in any one of a number of genes. There are over 70 genes in wt. S. typhimurium LT2.
Example of migration patterns among archive mutants.
A. Loss of motility mutant
B. Partial loss of motility mutant
C. LT2 wild type motility
WT |
S. Typhimurium LT2, Wild-type sequenced strain Contains fels-1, fels-2, gifsy-1 and gifsy-2 from Maloy |
2818 |
Phage-free S. Typhimurium strain received from A. Segall; SDT2739 S. entericaserovar Typhimurium LT2MA8507 (Gifsy-1− Gifsy-2− Fels-2−) ΔFels-1::frt; characterized further in reference: Gunderson |
Phage |
|
0-1 |
S. Typhimurium-specific bacteriophage characterized by Kropinski |
P22 |
S. Typhimurium –specific bacteriophage characterized by Kronpinski |
P27 |
S. Typhimurium-supernatant of CRC strain 1949 |
P53 |
S. Typhimurium bacteriophage P22 on strain CRC3895 |
P126 |
S. Typhimurium supernatant of CRC strain 2010 which contains gifsy-1, gifsy-2 |
P95 |
S. Typhimurium supernatant of CRC 1944 Pur E150 LT2 |
P153 |
S. Typhimurium Isolated from archival strain 2239 vs. nonarchival ATCC |
Table 1 Salmonella Typhimurium and Bacteriophages used in study our phage stock no. Strain History
14028 competition (see Phage P153 lysis pattern below)
The lysis patterns were:
Phage O-1- WT clear plaques 2/65, extra ring of growth in plaque.
Phage P22- Displayed cloudy plaques.
Phage P27- Cloudy plaques.
Phage P53- Cloudy,14/65 clear, 1/65 extra ring of growth.
Phage P95- Cloudy, 21,65 clear.
Phage P126- Normal clear plaques, 4/65 no visible plaque, 61/65 tiny clear spot only.
Phage P153-15/65 normal clear plaques, 2/65 cloudy, 48/65 tiny clearspots. Plaques of Phage P153 only arose when two other strains, S. typhimurium 2239 and 14024 where placed in competition with each other, resulting in the induction of a prophage harbored by one of the competing hosts.
[Figure 3 can go here]
We now know that facultative S. typhimurium can survive in sealed agar stabs, with depleting nutritional and oxygen supply. How much longer? The future generations of bacteriologists will be receiving the collection with the mandate to test for immortality and for future genomic changes (the genomic DNA sequences of a few archived strains are on record; also, all the Lillengen strains have been microarrayed). The concept of mutational change has had an interesting history. Starting with that of Darwin [offspring diversity-natural selection], challenged by Lysenko [environment as mutagen], clarified by Watson and Crick [chromosomal double helix knowledge], [occurrence only upon DNA replication], observations of mutations in resting, non-DNA synthesizing cells by Ryan,12 and the abundance of mutants among non-growing archived cells.
Among studies in our laboratory of decades old archived cultures of resting stage Salmonella typhimurium LT2, we have observed a series of diverse mutation patterns. The mutations included deletions, duplications, frame shifts, inversions and transpositions, and losses in carbon and nitrogen metabolism. A joy in the study of “Microbial Genetics” is to note “Eureka Moments,” especially those that involve contemporary scientists. Starting with some earlier history, the book by Charles Darwin On the Origin of Species (mutation-selection), Lysenko (environment as mutagen), the attack of Lysenkoism by Demerec, Dobzhanski of Lamarckan concepts of the heritability of acquired characteristics. Soon after, molecular geneticists tackled “mutation”. The Luria concept of errors in replicating DNA was refined to include alterations among resting, non-replicating DNA, especially the experiments of Frances Ryan,4 who showed that resting cell DNA could incorporate radioactive isotopes and 5-bromuracil. Among our own experiments, studies revealed that numerous mutations continue to occur in S. typhimurium LT2. Our immortal S. typhimurium LT2 strain, after some genomic engineering, is now a key experimental tool in targeting and impeding prostate tumor metastasis in TRAMP mice.12,13
Aging in higher organisms
Although there are many scientific studies on human aging, such as at the Newcastle University Institute for Ageing in Newcastle, G.B., investigators have not overlooked the need to understand factors at the biochemical and molecular level among the simpler organisms, including bacteria and viruses, such as the information in this Mini Review. We have enjoyed this venture. As might be expected, other microbiologists have provided very interesting data to the aging process in bacteria.15-17 Investigators have viewed the question of whether aged organisms, from bacteria to humans, have longevity advantage over parental wild type.11
This Mini Review emphasizes that S. typhimurium, stored for several decades in sealed vials, may still be capable of revival and genomic changes.
Numerous undergraduate, graduate, post doctorate, and laboratory technicians performed experiments that led to this review. Also, we recognize all individuals who have been involved in establishment of the strain collection, especially Dr. Demerec’s associate, Prof. James Wyche, who brought our share of the collection plus the original stock books, from Long Island to our lab. Currently, we acknowledge the tedious stenographic work through many edits of this mini review, Alycia McGee and Anna Vaclavek.
Professor Eisenstark designed all experiments describedor referenced in this mini review. The most recent experiments were performed by co-authors Jackie Kian Mehr and Joey Ransdell.
The authors declare no conflict of interest. The funding sponsors had no role in the design of the study; in the collection, analyses, or interpretation of data; in the writing of the manuscript, and in the decision to publish the result.

©2017 Eisenstark, et al. This is an open access article distributed under the terms of the, which permits unrestricted use, distribution, and build upon your work non-commercially.